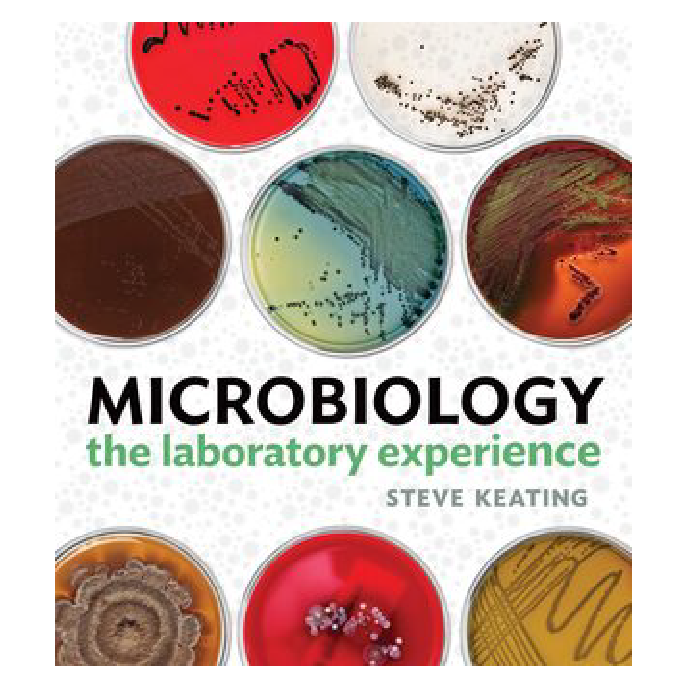
Microbiology: The Laboratory Experience book cover

At a time when other publishers are offering you and your students fewer choices, Norton continues to offer more. Whether your students prefer digital or print, we have options for everyone.
Value Options

Digital Access: $67.95*
This option gives students 180 days of access to the interactive ebook plus access to Smartwork, InQuizitive, animations, and Infectious Disease flashcards.

Paperback: $177.79* net
Our paperback option includes access to the interactive ebook plus access to Smartwork, InQuizitive, animations, and Infectious Disease flashcards.

Smartwork or InQuizitive standalone
*Prices subject to change. Third-party ebooks do not include most of the available interactive features and learning tools. Order Norton-delivered courseware from your bookstore to ensure your students pay the lowest price and have access to the most interactive ebook and the full learning experience. Access is for 180 days. Print prices listed are net prices at which Norton sells to the bookstore.
We offer microbiology labs at a discounted package price.
Add our printed lab manual or our digital microbiology labs to any of the options above for 20% off total cost.

Does your school offer an affordability option (such as inclusive access or equitable access)?
Norton is committed to affordability and partners with educational institutions and bookstores to enhance the effectiveness of this goal. Every Norton title is available for adoption within these programs, giving all of your students an equal opportunity to succeed.

Copyright © W. W. Norton & Company, Inc. 2026